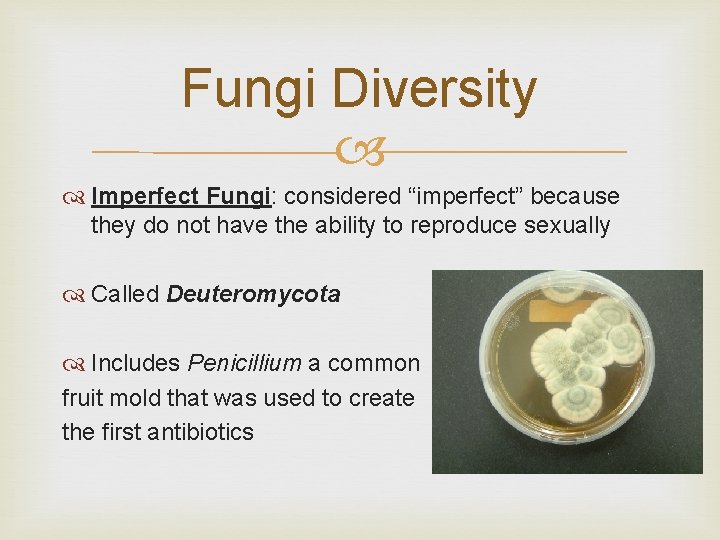
Fungi Diversity Imperfect Fungi: considered “imperfect” because they do not have the ability to

Fungi Basic characteristics types of fungi and reproduction

Fungi Basic characteristics, types of fungi and reproduction

Kingdom Fungi Eukaryotic Heterotrophic Multicellular (except for yeast) Have cell walls

Fungi Structure Cell walls of fungi are made of chitin Chitin is the same material that makes up the exoskeleton in insects

Fungi Structure Most fungi are made up of a structure called hyphae Hyphae: thread-like filaments

Fungi Structure A network of hyphae is called mycelium Functions: to provide an anchor and assist in digestion

Fungi Nutrition Fungi digest food through “extracellular digestion” They secrete digestive enzymes to break down food and then absorb it

Fungi Reproduction Fungi can reproduce both asexually and sexually Asexual reproduction occurs through budding or fragmentation and spores Budding requires a small piece of fungi to break off and become its own organism

Fungi Reproduction Sexual reproduction in fungi occurs through the creation of haploid cells called sporangium. The sporangium are then fertilized through the connection of two individual fungi by a stolon

Fungi Relationships Fungi often work closely with other species in their environment to fulfill different roles or niches Saprobes are decomposers that break down unwanted or dead organic material in the environment

Fungi Relationships Fungi can form mutualism with other species where both species benefit from the relationship Lichens: algae and fungi joined together to provide each other with necessary nutrients from their environment

Fungi Relationships Mycorrhiza: mutual relationship between plant roots and fungi where the plant increases the area it is able to absorb water from while the fungi get necessary carbon from the plant.

Fungi Relationships Fungi can also be parasites, living in a relationship with another species that harms the other species Athlete’s Foot: a fungal infection that feeds off of skin cells

Fungi Diversity Groups of fungi are classified according to how they look, reproduce, and what kind of spores they create Molds: fungi that grow on food products like meat, bread, fruits, etc. Called Zygomycota

Fungi Diversity Zygomycota species are divided into two parts: Rhizoids that act as roots and anchor the fungi Stolons that act as stems and push the spores up for dispersal to spread the mold

Fungi Diversity Sac Fungi: fungi that contain a sac for producing and distributing spores Called Ascomycota

Fungi Diversity Yeast: unicellular fungi that create spores called ascospores in sacs similar to sac fungi Ascospores become a dry powder used in baking that can be activated in water Reproduce asexually through budding once activated

Fungi Diversity Club Fungi: the most recognizable type of fungi are club fungi that reproduce in a club-like structure Called Basidiomycota Includes mushrooms, shelf fungi, and puff balls
Fungi Diversity Imperfect Fungi: considered “imperfect” because they do not have the ability to reproduce sexually Called Deuteromycota Includes Penicillium a common fruit mold that was used to create the first antibiotics

Fungi Diversity Fungi can be found in various environments and show a great diversity in their structures, types of reproduction, and roles within their environment. Fungal growth video
- Slides: 19